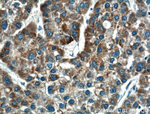
CPT1A Antibody in Immunohistochemistry (Paraffin) (IHC (P))
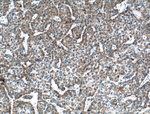
CPT1A Antibody in Immunohistochemistry (Paraffin) (IHC (P))
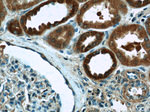
CPT1A Antibody in Immunohistochemistry (Paraffin) (IHC (P))

Search
Proteintech
CPT1A Polyclonal Antibody
{{$productOrderCtrl.translations['antibody.pdp.commerceCard.promotion.promotions']}}
{{$productOrderCtrl.translations['antibody.pdp.commerceCard.promotion.viewpromo']}}
{{$productOrderCtrl.translations['antibody.pdp.commerceCard.promotion.promocode']}}: {{promo.promoCode}} {{promo.promoTitle}} {{promo.promoDescription}}. {{$productOrderCtrl.translations['antibody.pdp.commerceCard.promotion.learnmore']}}
图: 1 / 24
CPT1A Antibody (15184-1-AP) in ICC/IF

产品信息
15184-1-AP
已发表种属
宿主/亚型
分类
类型
抗原
偶联物
形式
浓度
规格
保存条件
运输条件
产品详细信息
This antibody can bind the close sequences genes.
Immunogen sequence: QSLDAVEKA AFFVTLDETE EGYRSEDPDT SMDSYAKSLL HGRCYDRWFD KSFTFVVFKN GKMGLNAEHS WADAPIVAHL WEYVMSIDSL QLGYAEDGHC KGDINPNIPY PTRLQWDIPG ECQEVIETSL NTANLLANDV DFHSFPFVAF GKGIIKKCRT SPDAFVQLAL QLAHYKDMGK FCLTYEASMT RLFREGRTET VRSCTTESCD FVRAMVDPAQ TVEQRLKLFK LASEKHQHMY RLAMTGSGID RHLFCLYVVS KYLAVESPFL KEVLSEPWRL STSQTPQQQV ELFDLENNPE YVSSGGGFGP VADDGYGVSY ILVGENLINF HISSKFSCPE TGIISQGPSS DT (406-756 aa encoded by BC000185)
靶标信息
The mitochondrial oxidation of long-chain fatty acids is initiated by the sequential action of carnitine palmitoyltransferase I (which is located in the outer membrane and is detergent-labile) and carnitine palmitoyltransferase II (which is located in the inner membrane and is detergent-stable), together with a carnitine-acylcarnitine translocase. CPT I is the key enzyme in the carnitine-dependent transport across the mitochondrial inner membrane and its deficiency results in a decreased rate of fatty acid beta-oxidation. Alternatively spliced transcript variants encoding different isoforms have been found for this gene.
仅用于科研。不用于诊断过程。未经明确授权不得转售。




